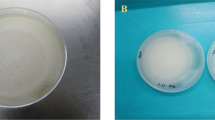

Abstract
SPECIMENS of this sponge collected at Calf Sound, Isle of Man, were investigated for spicules, and for their arrangement in the body of the sponge. Six types of spicules were found, ranging from very large tetraradiates and triradiates to long slender and minute rod-like oxea1. When the acid test was applied to a slide with dried spicules, all except the long slender oxea dissolved. These oxea are present in large numbers, and are set vertically in a palisade round the osculum.
This is a preview of subscription content, access via your institution
Access options
Subscribe to this journal
Receive 51 print issues and online access
$199.00 per year
only $3.90 per issue
Buy this article
- Purchase on SpringerLink
- Instant access to the full article PDF.
USD 39.95
Prices may be subject to local taxes which are calculated during checkout
Similar content being viewed by others
References
Bowerbank, J. S., “British Spongiadæ” 2, 36 (1866) (as L. nivea). Haeckel, E., “Die Kalkschwämme”, 2, 221 and Pl. 34. 1h. (1872).
Author information
Authors and Affiliations
Rights and permissions
About this article
Cite this article
EALES, N. Siliceous Spicules in the Calcareous Sponge, Leucandra johnstonii (Carter). Nature 172, 687 (1953). https://doi.org/10.1038/172687a0
Issue date:
DOI: https://doi.org/10.1038/172687a0